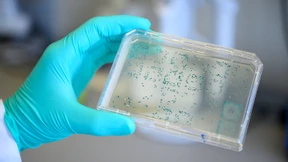
Noch mehr Fördergeld für Curevac

Verbraucherzentrale verklagt Lufthansa
Die Verbraucherzentrale Baden-Württemberg geht gegen die deutsche Fluggesellschaft wegen nicht erstatteter Flugtickets vor Gericht. Vorherige rechtliche Schritte waren demnach erfolglos geblieben.

Die Verbraucherzentrale Baden-Württemberg geht gegen die deutsche Fluggesellschaft wegen nicht erstatteter Flugtickets vor Gericht. Vorherige rechtliche Schritte waren demnach erfolglos geblieben.

Das Mineralbad Berg ist frisch renoviert. Für Stuttgarter ist das ein Quell der Freude. Die Liebe zu den Mineralquellen nimmt in der Stadt teils quasireligiöse Züge an.

Karlsruhe, Stuttgart, Konstanz: In drei Städten in Baden-Württemberg wird noch vor der Landtagswahl 2021 ein neuer Oberbürgermeister gewählt. Doch ausgerechnet die Grünen tun sich dort schwer.

Dieter Zetsche hat sein ganzes Leben für Daimler gearbeitet. Hier erklärt er, wieso jetzt Schluss ist, warum er doch nicht Aufsichtsratschef werden will und was er sonst noch so vorhat. Ein Hausbesuch.

Schlechte Aussichten für Geschädigte des Lastwagenkartells: Die Karlsruher Richter heben eine frühere Gerichtsurteil gegen Daimler auf, auf das sich viele andere Kunden in ihren Schadenersatzklagen berufen.

Die Opposition in Baden-Württemberg ist empört: Kultusministerin Eisenmann schert aus dem Kompromiss der Ministerpräsidenten für die Ganztagsbetreuung aus. Es geht um hohe Fördergelder.
Fünf Minuten bleiben für den Schutzanzug: Ein Intensivmediziner tauscht sich mit seinen Kollegen aus, um in Corona-Zeiten bestmöglich helfen zu können.

Ein Ermittlungsbericht über die „Partymeute“ belegt: Knapp drei Viertel der überwiegend jungen Männer war schon vorher durch Straftaten auffällig geworden. Und sie stammen aus Deutschland ebenso wie aus dem Ausland.

Unter der Ostsee soll ein langer Tunnel Deutschland und Dänemark verbinden. Der Widerstand ist heftig – aber nur in Deutschland. Ein Ortsbesuch.

Kein Vorschlag der FDP, sondern einer Grünenpolitikerin. Edith Sitzmann will kommende Woche im Bundesrat die Gesamtabschaffung des Solis fordern, wenn auch nicht ersatzlos.

Die Angst vor Ansteckung auf Reisen oder im öffentlichen Nahverkehr lässt die Nachfrage nach Bussen erlahmen. Als Gegenmaßnahme unterstützt der Hersteller Daimler seine Kunden etwa mit Finanzierungsangeboten.

Die Freien Demokraten stecken mal wieder in der Krise. Dabei stellten sie nach dem Krieg den ersten Bundespräsidenten und in Baden-Württemberg den ersten Ministerpräsidenten. Ein Rückblick.
Das Biotech-Unternehmen um Großaktionär Dietmar Hopp soll für die Entwicklung eines Impfstoffes gegen das Coronavirus eine Viertel Milliarde Euro vom Bund erhalten.

Die Schweizer vollenden ihr Jahrhundertwerk zur Querung der Alpen. Und das ohne große Verzögerung und Kostenexplosion. Deutschland ist mit dem Schienenanschluss in Verzug – um 15 Jahre.

Porsche steigt in die Entwicklung von E-Fuels ein. Dem VW-Chef dürfte das gefallen, darauf lässt zumindest ein Dialog zwischen Herbert Diess und Bill Gates schließen.

In Berlin protestierten bekannte Rechtsextremisten neben „normalen“ Bürgern. Was verbindet sie? Verfassungsschutzschützer aus Baden-Württemberg warnen: Extremisten dringen immer weiter in die Mitte der Gesellschaft vor.

Baden-Württembergs Wirtschaftsministerin will das geplante Unternehmensstrafrecht stoppen: Das sei „nicht gerecht“ und es bestehe das Risiko einer „willkürlichen und maßlosen Sanktionierung“. Jetzt hat sie sich mächtige Verbündete gesucht.

Der Parteitag der CDU ist in Gefahr. Geplant war in den Stuttgarter Messehallen die Wahl eines neuen Vorsitzenden, der auch Kanzlerkandidat werden könnte. 1001 Delegierte sollen kommen. Müssen sie sich den Corona-Auflagen beugen?

Das Ende 2018 gestartete Experiment mit 23 Luftfiltersäulen am Stuttgarter Neckartor ist allen Zweiflern zum Trotz als Erfolgsgeschichte zu bewerten. Sowohl die Messwerte für Feinstaub als auch für Stickstoffdioxid sanken.

Nach dem Milliardenvergleich in Amerika wird plötzlich auch der Schadenersatz für Mercedes-Fahrer in Großbritannien zum Thema für die Stuttgarter. Die Klägeranwälte sprechen vom „höchsten Volumen in der schottischen Rechtsgeschichte“.

Baden-Württemberg will durch eine Bundesratsinitiative eine schärfere Prüfung für Genossenschaften auf den Weg bringen. Auslöser ist der Betrugsfall der Genossenschaft Eventus.

Die oberste Führungsriege von VW im Dieselskandal muss weiterhin keine strafrechtlichen Folgen befürchten. Die Staatsanwaltschaft Stuttgart stellt ihre Ermittlungen gegen den VW-Aufsichtsrat Pötsch gegen Zahlung einer Geldauflage ein.

In Umfragen bekommt die IG Metall für ihren Vorstoß kräftigen Zuspruch. Viele Autohersteller und ihre Zulieferer reduzieren die Arbeitszeit schon jetzt. Umstritten bleibt der Lohnausgleich.

Von AAA auf AA+ mit stabilem Ausblick: Die Ratingagentur Standard & Poor’s stuft das Bundesland Baden-Württemberg ab – wegen Corona.

Akribisch wurde die Provenienzgeschichte der Bilder für ein geplantes NS-Museum für Schwäbische Kunst in Stuttgart untersucht. Dabei fand sich auch viel Neues aus der Übergangszeit der Malerei zwischen Weimarer Republik und Nationalsozialismus.

Leben wir in einer „Corona-Diktatur“? Der Kabarettist Florian Schroeder hat die Teilnehmer einer Demo gegen die Corona-Maßnahmen provokant mit seinen Ansichten dazu konfrontiert. Im Interview spricht er über seinen Auftritt in Stuttgart.

Bei der „Querdenken“-Demo tritt der Kabarettist Florian Schroeder auf – und konfrontiert das Publikum mit Corona-Regeln und Überlegungen zu Meinungsfreiheit. Die Menschen klatschen und buhen ihn aus.

Auch diesen Samstag hat die Initiative „Querdenken 711“ zur Demonstration gegen die Corona-Beschränkungen aufgerufen – und präsentiert mit Thomas Berthold einen berühmten Redner. Der Fußball-Weltmeister von 1990 fordert eine neue Partei.

Mitte Juni hatten viele Krankenhäuser keine Covid-19-Patienten mehr; jetzt beobachten sie eine leichte Zunahme. Man habe aber aus den ersten Fällen gelernt und sei gut gerüstet, versichert ein Klinikdirektor aus Aaachen.

Voll vernetzt und voll flexibel soll die Fabrik sein, in der Daimler die neue S-Klasse produzieren wird. Schon im September geht es los.

Frauenparkplätze werden abgeschafft, Mädchennamen ebenso. Nicht mehr zeitgemäß, findet man im Stuttgarter Rathaus. Also nicht die Dinge als solche, aber die Worte dafür. In Baden-Württemberg ist eine Debatte entbrannt.

Dass die Demonstration gegen die Corona-Politik so viel Zulauf bekommen hat, hat mit der Professionalisierung der Organisatoren, gezielter Werbung, einem Bündnis mit einem Busunternehmerverband und dem AfD-„Flügel“ zu tun.

Wegen der Absagen durch die Pandemie haben viele Schausteller in diesem Jahr nicht einen Euro umgesetzt. Nun hoffen sie im Herbst auf Bremen und Hamburg.

Laut Lebensmittelüberwachung in Baden-Württemberg weist die Hälfte der hanfhaltigen Lebensmittel einen zu hohen THC-Gehalt auf.

Hans-Jörg Vetter hat zwei Landesbanken aus der Krise geführt. Nun dürfte er neuer Aufsichtsratschef der Commerzbank werden. Seine erste Aufgabe: einen neuen Vorstandschef finden.

Immer mehr Prozesse wegen des Dieselskandals bringen die Richter an den Rand der Belastungsgrenze. Und jetzt gerät auch noch EY ins Visier, nicht nur wegen Wirecard.